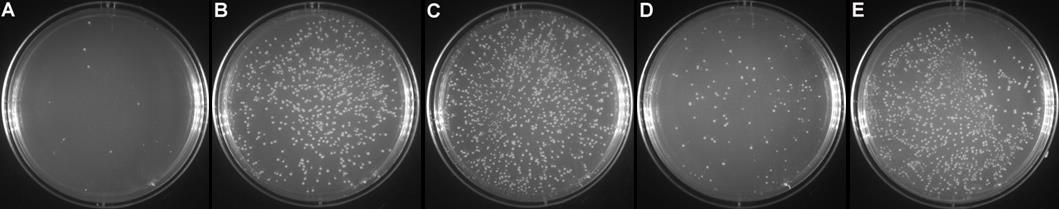
https://img1.dxycdn.com/p/s14/2024/0418/862/2194989213603370871.jpg

相关产品推荐更多 >
万千商家帮你免费找货
0 人在求购买到急需产品
- 详细信息
- 文献和实验
- 技术资料
- 库存:
大量
- 英文名:
Rapid DNA Ligation Kit
- 保质期:
一年
- 供应商:
上海联迈生物工程有限公司
- 保存条件:
-20℃保存
- 规格:
100次
| 产品编号 | 产品名称 | 产品包装 | 产品价格 |
| LM7002 | 快速DNA连接试剂盒 | 100次 | 173.00元 |
本试剂盒可以用于PCR片段和载体的连接、酶切产物和载体的连接、linker和载体的连接、linker和linker的连接等各种双链DNA的连接。
为了获得快速高效的连接效果,本试剂盒采用了一种特殊的高活力Rapid T4 DNA Ligase以及相应的快速连接缓冲液,确保在短时间内可以获得很好的连接效果。连接30分钟和连接过夜的效果相当,通常只须连接5-10分钟即可满足常规用途(图1)。
图1.快速DNA连接试剂盒实测效果图。双酶切后的载体室温自连30min(A)或16℃自连过夜(D)作为阴性对照;双酶切后的载体与待插入片段室温连接10min(B)、30min(C)或者16℃连接过夜(E),随后转化细菌涂板,并于第二天取平板观察拍照。
在确保连接效果的同时,确保完成连接后不必进行任何纯化即可直接转化细菌。另外,快速连接缓冲液中已经含有ATP、镁离子等各种必需物质,无需再添加其它任何试剂。
本试剂盒用于总体积为10μl的连接体系时可以进行100个连接反应,用于总体积为20μl的连接体系时可以进行50个连接反应。
包装清单:
| 产品编号 | 产品名称 | 包装 |
| LM7002-1 | 快速连接缓冲液(2X) | 0.5ml |
| LM7002-2 | Rapid T4 DNA ligase | 50μl |
| — | 说明书 | 1份 |
-20℃保存。
注意事项:
连接反应完成后即可直接转化细菌,请勿采用加热方法失活Rapid T4 DNA ligase。加热处理会导致后续的转化效率显著下降。
对于载体单酶切插入外源片段的情况,需注意对载体进行脱磷处理,以避免质粒自连。
快速连接缓冲液(2X)使用前一定要完全溶解并混匀,加入到连接体系后也须注意混匀。
本产品仅限于专业人员的科学研究用,不得用于临床诊断或治疗,不得用于食品或药品,不得存放于普通住宅内。
为了您的安全和健康,请穿实验服并戴一次性手套操作。
风险提示:丁香通仅作为第三方平台,为商家信息发布提供平台空间。用户咨询产品时请注意保护个人信息及财产安全,合理判断,谨慎选购商品,商家和用户对交易行为负责。对于医疗器械类产品,请先查证核实企业经营资质和医疗器械产品注册证情况。
 文献和实验
文献和实验【交流】关于NEB的T4 DNA连接酶和快速连接试剂盒的常见问题及解答
连接酶,反应10分钟。平滑末端连接:在20µl反应体系中加入1µl T4 DNA 连接酶反应2小时,或者加入1µl高浓度T4 DNA 连接酶反应10分钟。 另外,NEB的快速连接试剂盒 (Quick Ligation Kit, NEB #M2200V [15个反应])是独有的可以在室温5分钟条件下连接平滑末端和粘性末端的试剂盒。 图1:在25°C条件下,用1 unit(1:400稀释后取1 µl)T4 DNA连接酶连接λDNA/Hind Ⅲ片段(4-碱基粘端)不同反应时间的结果。 图
相关专题 重组DNA技术工具酶 DNA连接 酶对所连接的DNA两端碱基序列是否有专一性要求? 一、矛盾之处: (一)DNA连接 酶对所连接的DNA两端碱基序列不具有专一性要求 支持这一观点的是2008年江苏高考32题,请看具体内容及图示,如下: 32.(8分)将动物致病菌的抗原 基因导入马铃薯制成植物疫苗,饲喂转基因马铃薯可使动物获得免疫力。以下是与植物疫苗制备过程相关的图和表
采用了公司最亲斤发明的特殊中和液Buffer N8,可使用户在8分钟内快速从1~5 ml细菌培养物(LB培养基)中提取多至30 mg高纯度的质粒DNA,适用于测序、体外转录与翻译、限制性内切酶消化、细菌转化、强壮细胞转染等分子生物学实验。
 技术资料
技术资料暂无技术资料 索取技术资料










